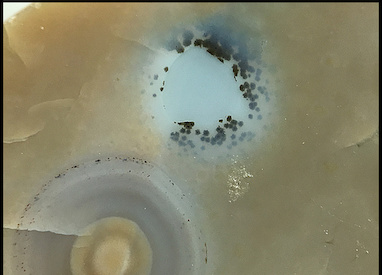

Zoning and spherulite banding in Ocean Jasper
(Scroll down for text)

Zoning in rock formations is broadly defined as a spatial inhomogeneity that occurs from nonequilibrium dynamic processes such as reaction-diffusion, whereby intensive variables (e.g. density, temperature, pressure, viscosity) are changing rapidly and the system is thrown out of equilibrium into a kinetic nonequilibrium state. Such processes result in the pattern formation we see in Ocean Jasper, including color zoning and crystal structure zoning.
Color zoning in the Ocean Jasper matrix is ubiquitous in specimens, and can occur on large and small scales. Two examples of large scale matrix color zoning are shown above, Specimen 1 with a white to green opaque matrix transition, and Specimen 2 with a white to green opaque to gray bluish-yellowish translucent transition. These may appear to some as a "layer", but they are more aptly classified as a broad matrix color zone that occurs in a nonequilibrium fluid medium due to chemical differences, and this is supported by lab characterization studies of samples from each of the matrix zones in Specimen 2. Specifically, the green zone shows much more concentration of (green) iron content than the white opaque or yellowish translucent zones, as measured by a scanning electron microscope (SEM) with an energy-dispersive x-ray (EDX) detector.
Smaller scale color zoning is shown in Specimen 3 as "wisps" of white or other colors, again occurring as smooth waves of chemical concentration differences in a viscous fluid medium.
Crystal structure zoning is also ubiquitous in Ocean Jasper specimens, as evidenced by Specimen 2, with two relatively opaque matrix color zones and one relatively translucent. Though all three zones have clearly defined canonical quartz crystallographic structure, as evidenced via powder x-ray diffraction (XRD) sample testing, the latter translucent samples tested out with slightly different peak strengths commensurate with a translucent chalcedony, and the former two with peak strengths commensurate with macrocrystalline quartz (these were compared in my Mindat study to standards published in the referenced research literature). The "holes" in Specimen 4a-b showing more predominant macrocrystalline quartz structure are a result of a gel-sol fluid hardening under the condition of a lower water concentration, with an inhomogeneous spatial contraction of hardening material. Such a phenomenon occurs over large scales in some Ocean Jasper specimens, such as Specimen 4a-b, or on a smaller isolated scale, such as Specimen 2. Quartz druzy pockets and growth on botryoidal chalcedony habits are quite common in most Ocean Jasper specimens.
The spherulites within each matrix zone are another example of coordinated crystal structure zoning. As explained HERE, spherulites are formed from density fluctuations or impurities, randomly distributed in the ferrous-silica precursor solution. Nucleation of spherulites leads to a first order phase transition, and outward growth from a microscopic crystal point in a fibrous chalcedony habit. Such outward growth is accompanied by reaction-diffusion processes in the interspersed gel-sol fluid, namely reactions leading to precipitation of iron oxide and hydroxide particulates, and an outward diffusion of such particulates, primarily in the absence of convection. This is the source of the observed spherulite banding in Ocean Jasper, with complexity and size not seen elsewhere in the orbicular rock world. In particular, the near-perfect spherical shape of large spherulites (10-25mm) in high grade Ocean Jasper would not occur in a medium other than a gel-sol fluid that has correlated time scales for hardening and the opportunity of the suspension that leads to such a spherical shape, as opposed to an oblate shape, though such shapes also occur in high grade specimens, and result from surrounding fluid viscosity and pressure differentials. "Liesegang rings" observed across numerous modalities in nature are a result of reaction-diffusion processes, as described.
All of this leads to the question of whether Ocean Jasper is formed from a supercooled, supersaturated ferrous-silica solution with nonequilibrium density fluctuations and impurities, or some other model. I discuss this at length in the published book, and I've mentioned in several posts on this website and on Instagram that later weathering and intrusion of impurities are indeed possible after the first hardening phases. Two prime examples are the observation of silica solution backfilling in brecciated Ocean Jasper, as in Specimen 5, and mossy inclusions in post hardening gaps in spherulites, as in Specimen 6. These observations are from relatively non-invasive post-hardening weathering.
Some have suggested that "metamorphic" processes are responsible for the formation of Ocean Jasper, from "layers" to macrocrystalline matrix structure. This is not substantiated by the evidence. The definition of "metamorphic rock" given on Mindat is: "Any rock derived from preexisting rocks by mineralogical, chemical, and/or structural changes, essentially in the solid state, in response to marked changes in temperature, pressure, shearing stress, and chemical environment, generally at depth in the Earth's crust." Metamorphic rock is considerably altered in its original solid state to another distinguishable state. Typical examples are heavily weathered and altered rock, such as schist, tektite, granitic gneiss, solid rock altered under considerable pressure or temperature differentials. Clearly this does not apply to Ocean Jasper ("spherulitic chalcedony"). Yes, relatively non-invasive weathering has been observed, but not the type of changes observed in metamorphic rock. The fine/refined features in Ocean Jasper are from a relatively pristine original formation, as described in the above examples of zoning and spherulitic banding.
The ferrous-silica formation model I describe here was originally proposed in the 2019 published book Ocean Jasper: A Natural Wonder and a Geological Mystery. I encourage readers who want to know more to purchase the book, as it includes not only an explanation of this model, but a description of the mining history and unknown geological information, a grading scale of Ocean Jasper based on complexity, and a comparison of "spherulitic chalcedony" with conventional agates and orbicular jaspers. All author proceeds are donated to research studies, and to the upkeep of this website as a living document for specimen photos and dissemination of research information.



